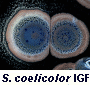
streptomyces coelicolor igf

Dept of Biochemistry, Cell & Systems Biology, Institute of Systems, Molecular and Integrative Biology, University of Liverpool,
Liverpool L69 7ZB
![]() |
![]() |
![]() |
![]() |
![]() |
![]() |
![]() |
![]() |
![]() |
![]() |
![]() |
![]() |
![]() |
![]() |
![]() |
![]() |
![]() |
![]() |
![]() |
![]() |
![]() |
![]() |
![]() |
General information
Most of our bioanalytical projects are at the interface between postgenomic biological systems, quantitative analytical chemistry and machine learning, with a special emphasis on evolutionary computing and systems biology. We have particular interests in chemical genomics, network biology and e-science. Other areas include pharmaceutical drug transporters, iron as a major cause of disease, and synthetic biotechnology, and the role of amyloidogenic clotting in chronic, inflammatory diseases, especially Long COVID.
People
Bioanalytical Sciences Group |
|||
Academic staff: |
|||
![]() |
Prof Douglas Kell Head of GroupDouglas.Kell[AT]liverpool.ac.uk Present Blog Previous (BBSRC) Blog |
![]() |
Mrs Julie Cowley Executive Assistant to Professor Kell |
Manchester University Collaborators: |
|||
![]() |
Dr Steve O’Hagan Computer Officer sohagan[AT]manchester.ac.uk +44 161 30 64562 |
||
Post Doctoral Researchers: |
|||
| Dr Justine Grixti, Dr Ivayla Roberts, Dr Simon Zhu | |||
Ph.D. Students: |
|||
| Dory Nicoletti | |||
| Some past members: | |||
| Dr Nicholas Ludtke, Dr Yang Liu, Dr Anthony Halsall, Dr Dieter Weichart, Dr Karin Lanthaler Dr Yoshi Tsuruoka, Dr James Marsh, Ms Nadine Harding, Dr David Broadhurst, Dr Paul Dobson, Dr Peter Li, Ms Sue McIntyre, Dr Neil Hayes, Dr Yogendra Patel, Dr Evangelos Simeonidis, Dr Jason Ashworth, Dr Marie Brown, Ms Maureen Cameron, Dr Elizabeth Davies, Miss Joanne Ellis, Mr Mike Evans, Dr Caroline Farrelly, Dr Julia Handl, Dr Adaoha Ihekwaba, Dr Bayu Jayawardhana, Dr Yankuba Kassama, Dr Chris Knight, Miss Hongmei Lu, Dr Hailin Shen, Mrs Katya Tarasova, Dr Charles Twist, Dr Steve Wilkinson, Dr Rebecca Williams, Miss Peng Xiaofang, Dr Jin Yisu Dr Hong Yue, Dr Hongjuan Zhao, Dr Paul Begley, Dr Duncan Hull, Dr Mark Platt, Dr Will Rowe, Dr David Thorne, Dr Andy Tseng, Dr Giles Velarde, Dr Alice Villéger, Dr Yunjiao Wang, Dr Thomas Williamson, Dr Eva Zelena, Prof Irena Spasic. | |||
Collaboration
We also have close research collaboration with the members of following research groups:
- Manchester Centre for Integrative Systems Biology
- The Laboratory for Bioanalytical Spectroscopy, headed by Prof. Roy Goodacre.
Visitor information
Visitor information can be found here.
Contact details
We prefer to be contacted by e-mail. You can use the addresses listed above to contact any of us. If you wish to contact the head of the group, Prof. Douglas Kell, please use the following contact details:
E-mail: Douglas.Kell[AT]liverpool.ac.uk
[lastupdated]

Follow Prof Kell!